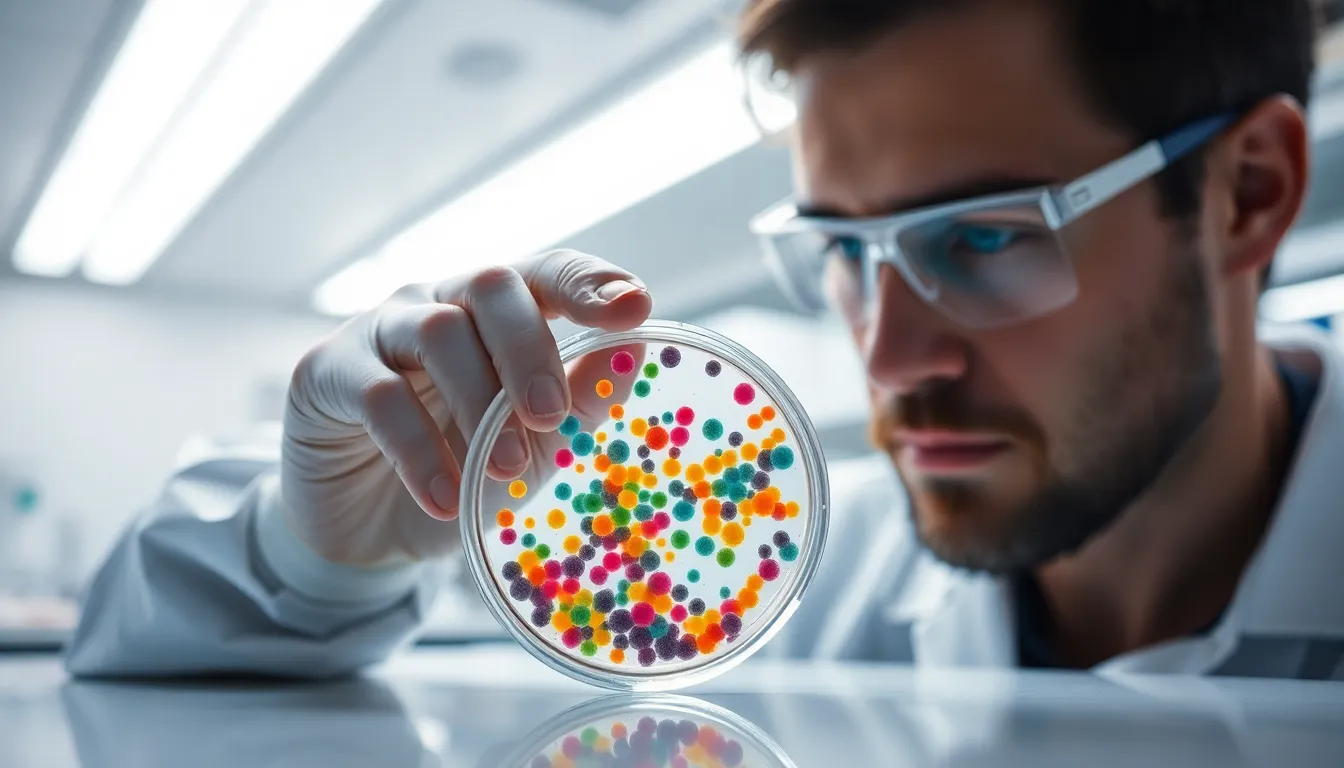
Scientist Analyzing Bacterial Cultures
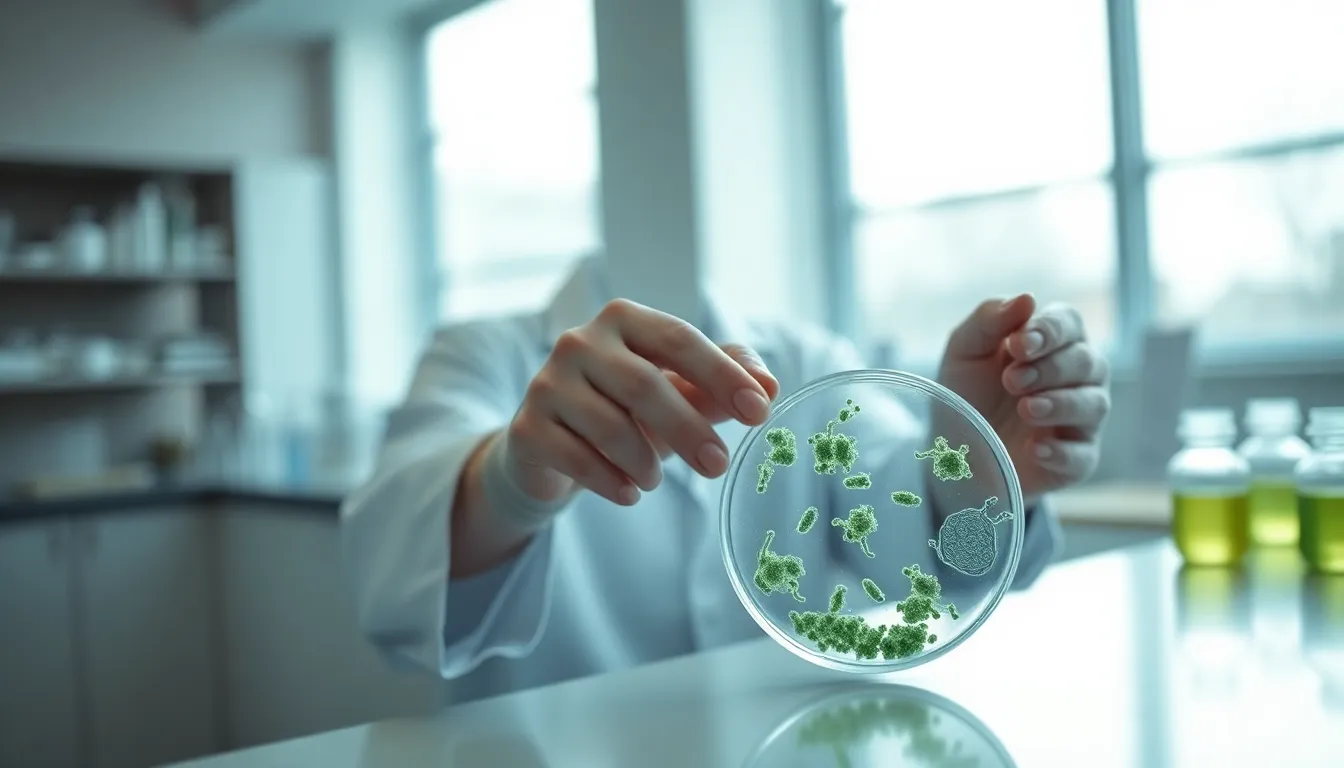
Scientist Using Pipette in Modern Laboratory

Related Tags

Scientist Analyzing Bacteria in Laboratory

Scientist in Modern Laboratory

Scientist Using Microscope in Laboratory

Late-Night Laboratory Experiment Setup

Scientist at Work with DNA Sequencing Tools

Scientist Observing Chemical Reactions

Female Scientist Working in a Laboratory

Dedicated Scientist Analyzing Cultures

Scientist Analyzing Colorful Liquid Solutions

Biologist Examining Bacteria Cultures

Scientist Analyzing DNA Structure

Scientist Working With DNA Model

Scientist Using Pipette in Modern Laboratory

Lab Technician Examining Samples Under Microscope

Scientist Analyzing Petri Dish in Laboratory

Scientist with Digital DNA Model in Modern Lab

Scientist Analyzing Test Tube in Laboratory
Scientist Analyzing Bacterial Cultures

Scientist Analyzing Digital DNA Data

Scientist Analyzing DNA Sequence

Scientist Analyzing DNA Sequencing Chip

Scientist Conducting Experiments in Laboratory

Scientist Analyzing DNA Sequencer

Scientist Working in a Modern Lab

Scientist Working on Holographic Display in Spacecraft

Scientist Examining Samples in Laboratory

Scientist Examining Slide Under Microscope

Scientist Examining Petri Dish in Laboratory

Scientist Analyzing DNA Sequences

Scientist Analyzing Petri Dishes in a Lab

Scientist Examining Vial in Laboratory

Scientist Planting Seeds in Biodegradable Pot

Scientist Holding DNA Helix Model in Studio

Scientist Analyzing Microbial Cultures in Lab

Scientist Examining DNA Structure Model

Scientist Handling DNA Samples in Lab

Scientist Examining Soil Samples

Dedicated Scientist Analyzing Specimen in Laboratory

Scientist in Laboratory

Scientist Examining Petri Dish in Laboratory

Organic Chemistry Lab Scene with Chemist at Work

Microbiologist Analyzing Petri Dishes in Laboratory

Chemist Pouring Solution in Bright Laboratory

Scientist Observing Chemical Reaction in Laboratory

Researcher Analyzing Samples in Modern Lab

Scientist Examining Samples in Laboratory

Scientist Analyzing Petri Dish in Laboratory

High-Tech Space Station Laboratory Interior

Scientist's Hands Conducting Experiment in Lab

Scientist at Work in Laboratory

Scientist Holding Glowing Orb in Lab
Scientist Examining Petri Dish in Laboratory

Scientist Analyzing Holographic Data

Close-Up of Scientist Mixing Chemicals

Scientist Observing Chemical Reaction

Scientist Experimenting with Particle Accelerator

Outdoor Chemistry Experiment at Golden Hour

Close-Up of Chemist at Work with Microscope

Scientist Analyzing Samples Under Microscope

Scientist Collecting Soil Samples in Nature

Scientist Mixing Chemicals in the Lab

Dramatic Chemical Reaction in a Laboratory

Dedicated Scientist Analyzing Samples Under Microscope

Scientist Analyzing DNA Sequencing

Scientist Conducting Experiment in Modern Lab

Scientist Working in Bright Laboratory

Scientific Research in DNA Analysis

Scientist Engaging with Holographic DNA Model

Scientist Working with Petri Dish

Scientist Analyzing Samples in Fume Hood

Scientist Operating Laser Equipment in Laboratory

Scientist Examining DNA Sequencer in Laboratory

Scientist Examining Petri Dish in Laboratory

Pipetting Liquid in Laboratory Close-Up

Scientist Examining Samples Under Microscope

Excited Scientist in Laboratory

Scientist Pouring Solutions in Modern Laboratory